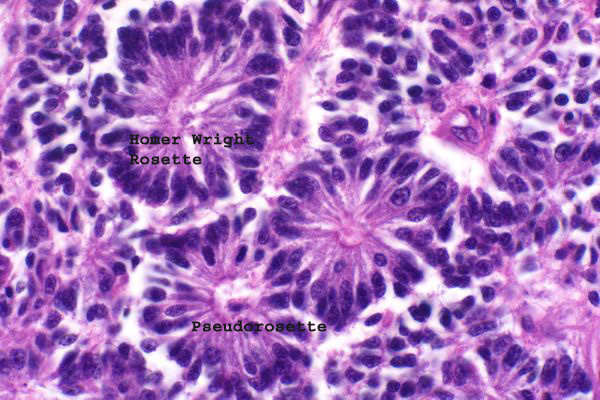

| 40x | Hematoxylin and Eosin | ||||
| Close Window | Macro View | Show Help | Back | |
|
Neoplastic cells pallisade around a blood vessel (pseudorosette). Homer-Wright rosettes lack a central lumen. Click on show help.
|
||||
|
||||
| Return | ||||
|
Neoplastic cells pallisade around a blood vessel (pseudorosette). Homer-Wright rosettes lack a central lumen. Click on show help.
|
||||